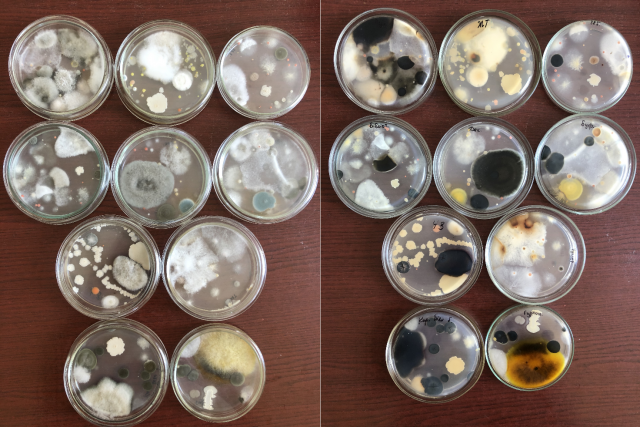

Вивчення дисципліни «Нормативне забезпечення біотехнологічних виробництв» студентами-біотехнологами
На 2 курсі, студенти-біотехнологи спеціальності 162 «Біотехнології та біоінженерія», почали вивчати дисципліну «Нормативне забезпечення біотехнологічних виробництв». Розробка і виготовлення конкурентоспроможної біотехнологічної продукції, що втілюють сучасні досягнення науки, неможливі без широкого застосування принципів та методів технічного регулювання та його складових: стандартизації, оцінки відповідності та метрології, які є інструментами забезпечення якості продукції, робіт і послуг галузі біотехнології — важливого аспекту багатогранної комерційної діяльності. На лекційних заняттях ми ознайомились з сучасним станом технічного регулювання в Україні, структурою законів, технічних регламентів, стандартів.

На лабораторних заняттях ми провели аналіз мікрофлори повітря різних приміщень навчального корпусу факультету та студентського гуртожитку седиментаційним методом. Дослід виконувався у навчальній лабораторії факультету захисту рослин, біотехнологій та екології.
Серед мікроорганізмів переважали бактерії родів Bacillus, Clostridium, Micrococcus, Sаrcina, Serratia, цвільові гриби.

За результатами дослідження було встановлено, що кількість мікроорганізмів коливалась від 2,1× 102 до 10,7× 103 КУО м3, що залежало від частоти вологих прибирань, дезінфекції та провітрювання приміщень. Також нами було визначено загальну кількість мікроорганізмів (мезофільних аеробів і факультативних анаеробів – КМАФАМ) в 1 мл різних зразків води та виявлено санітарно-показові мікроорганізми (бактерії групи кишкової палички (БГКП) родини Enterobacteriaceaе).
Перспективи створення нормативних документів потребують знання з цих напрямків, необхідні майбутнім спеціалістам для науково обґрунтованого вирішення завдань у сфері біотехнологічних виробництв.
Вільховий Сергій, студент-біотехнолог 2 курсу
Бородай Віра, доцент кафедри екобіотехнології та біорізноманіття